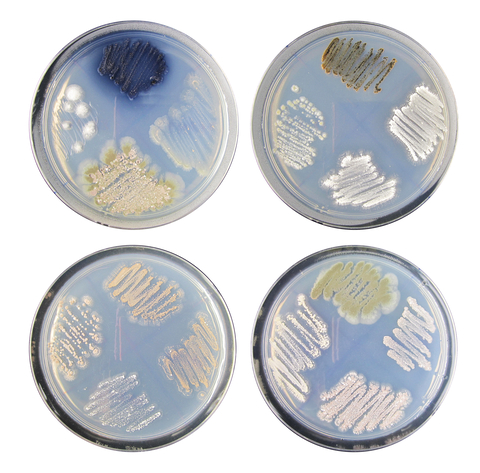
actinomycetes

Before You Go
Get Your FREE Home Cleaning Guide
Simple action items on how to make your home safer- today!

You’ve probably heard of bacteria and fungi lurking in your home, but did you know there’s a group of bacteria that blends the traits of both? Meet actinomycetes—the group of actinobacteria that like to think they’re mold. These bacteria are natural-born recyclers in the environment, breaking down organic matter in soil and keeping nature’s systems running smoothly. But when they creep into your home, things can get messy—literally. Think of them as nature’s clean-up crew gone rogue, wreaking havoc on your walls, air quality, and possibly your health.
Curious to learn more about how actinobacteria could be lurking in your home? Let’s dive into what makes these bacteria tick, where they hide, and, most importantly, how to keep them from turning your home into their next breeding ground.
Actinomycetes are a unique group of bacteria that have a lot in common with mold—and not just in appearance. These gram-positive bacteria are known for their ability to grow in colonies, spreading in a way similar to fungi, thanks to their thread-like structures called hyphae. Like mold, they can produce spores, allowing them to thrive in many environments. You’ll find them in soil, water, and even inside living organisms, including humans.
The real issue comes when actinomycetes move indoors, especially after water damage. Much like mold, they start breaking down organic materials in your home—like wood and drywall—and releasing spores into the air. This can lead to serious structural and indoor air quality issues. If exposed to that poor air quality for too long, you could start experiencing health problems like with mold exposure.
Actinomycetes can be beneficial and harmful, depending on the species and circumstances. On the positive side, many species within this group are crucial to ecological and human health. For instance, Streptomyces, a genus of Actinobacteria, is a natural producer of antibiotics, such as streptomycin and tetracycline, widely used to combat bacterial infections in humans and animals.
However, some species of Actinobacteria can be harmful. While the full picture of negative health effects caused by actinomycetes is not yet fully understood, research has concluded that exposure to actinomycetes in water-damaged buildings was significantly linked to decreased lung function, asthma-like symptoms, and symptoms similar to granulomatous disease, including shortness of breath, aching, fever, and chills.
Actinomycetes may have a greater effect on those with existing chronic respiratory illnesses and those with weakened immune systems. Studies have been conducted to develop a link between the presence of indoor actinomycetes resulting from water damage in buildings and those suffering from Chronic Inflammatory Response Syndrome, or CIRS. Exposure to indoor actinomycetes has also been linked to Extrinsic Allergic Alveolitis (EAA), also known as Hypersensitivity Pneumonitis (HP), a lung disease marked by inflammation. Symptoms of EAA/HP can include asthma-like symptoms, flu-like symptoms, malaise, and weight loss. These non-specific symptoms can frequently result in misdiagnosis.
Not to mention, the antibiotic metabolites naturally produced from actinomycetes may harm natural gut bacteria in humans, much like an intense antibiotic regimen prescribed by a doctor can. The more research is done on the health effects of actinomycetes, the clearer it becomes that we should try to avoid exposure in our homes whenever possible.
One of the most notable diseases caused by Actinobacteria is actinomycosis. This chronic infection often occurs in the face, neck, chest, or abdomen and is usually caused by Actinomyces species, a type of Actinobacteria. Symptoms include painful swelling, abscesses, and tissue damage, often resembling other infections or tumors, making it tricky to diagnose.
Another potential health concern involves Nocardia species, another member of the Actinobacteria family, which can lead to nocardiosis. This condition primarily affects the lungs but can spread to other organs, particularly in individuals with compromised immune systems.

When Actinobacteria grow indoors, especially in environments with high moisture and poor ventilation, they can have a variety of negative effects on both the home and its inhabitants.
In short, while Actinobacteria are a natural part of many environments, their growth indoors—especially in conditions that allow bacteria to thrive—can severely harm indoor air quality and pose risks to human health, particularly for those who are vulnerable.
Actinobacteria, particularly actinomycetes, can be surprisingly common in the home, especially after a water damage event. These bacteria need specific conditions to thrive, and unfortunately, many homes provide exactly what they’re looking for, including organic materials, moisture, and oxygen. Actinomycetes and mold often co-colonize in water-damaged environments because they share similar growth needs. Both require food sources like cellulose, abundant in materials such as drywall and wood framing.
To break it down, drywall is often made with a paper backing that contains cellulose, a favorite food for actinomycetes. Combine that with moisture from leaks, floods, or high humidity, creating an ideal environment for these bacteria to grow. Given that so many homes are made with drywall and lumber, it’s easy to see how actinomycetes can rapidly establish themselves in your home after water damage.

These bacteria tend to flourish in areas like basements, attics, or around leaky windows where moisture lingers. Not all actinomycetes need oxygen to grow; some species are anaerobic, meaning they can survive in low-oxygen environments, like within the walls or in damp, poorly ventilated spaces.
Once they start growing, actinomycetes can degrade the materials in your home and spread spores into the air. This affects the structural integrity of your house and compromises indoor air quality, which can lead to health issues for anyone living in the space. Co-colonization with mold further amplifies these risks, as both microorganisms release harmful particles that can irritate the lungs and weaken the immune system.
So, if you’ve experienced any water damage, it’s crucial to act quickly to prevent mold and actinomycetes from taking hold. Proper drying, repairing, cleaning, and cleansing the air can help reduce the risk of bacterial and mold growth in your home.
Understanding how to properly eliminate actinomycetes is key to ensuring they don’t negatively impact your health and home.
If you’re dealing with a little problem, your first step will be to determine the type of surface you’re working with.
For actinomycetes on nonporous surfaces like metal, and the issue that led to the growth is resolved, you can remediate it using a botanical cleaner like Benefect Decon 30. Spray this on the surface and allow it to sit for 30 seconds. After this dwell time, wipe the surface with a microfiber cloth, as they are 100 times better at removing small particles. Repeat the process two times, allowing the cleaning product to sit for 30 seconds to ensure all particles are removed. These are particularly difficult to remove from a surface, which is why a thorough process is required. Use a different side of the microfiber cloth with each wipe, then throw it away afterward.
Actinomycetes on semi-porous surfaces, such as hardwood, need an abrasive technique to remove the roots, which can grow into the surface and be difficult to remove. Small particles could have also burrowed within the fibers of the surface. From there, a thorough remediation process can be used to eliminate the particles present, and then the surface should be sealed. This comprehensive process is necessary because it can grow right back if the roots are left behind. On the other hand, exposure will continue if contaminants are still present.
For porous items like clothing, it is best to throw them away and start fresh with a new item to remove all contamination. The fibrous nature of the item makes it incredibly difficult to remediate successfully.
Keep in mind that when you remediate the surface, particles will become airborne during the removal process. To help protect yourself and your home from the particle party, set up proper engineering controls, wear personal protective equipment, and create a containment area.
After remediation, deep clean the surrounding area to remove any dust and particles released while the growth was active. It is also incredibly important to clean the HVAC afterward.
When a bigger contamination problem arises, a qualified remediation company should be brought in to address it. Not all remediation teams are built the same, though. The remediation company chosen should prioritize the clients' health above all else. They should also have proven experience in successfully dealing with toxic environments so their clients can return home to heal. That is the ultimate goal.
Their protocol should be based on three main pillars to achieve this success.
If any of these boxes aren't ticked, the project will be unsuccessful. The growth could come right back, or contamination could be left behind, allowing exposure to continue—both of which are wellness no-nos.
During this process, it’s also a great idea to find a medical professional who is well-versed in exposure to poor indoor air quality, can identify related symptoms, and knows how to eliminate those toxins from the body. Healing from exposure involves creating a safe environment that allows for recovery and gives the body the necessary things to get back into balance.
Include “Book Consultation” button with link to services
Preventing actinobacteria from flourishing in your home is all about managing moisture and creating an environment discouraging their growth. Here are some effective steps you can take to keep these bacteria—and the health risks they bring—at bay:
This is a great starting point to help prevent actinomycetes from growing in your home.
Woo Commerce Link to Cleaning Products, Kits, and Air Purifiers

Micro Balance EC3 Mold Solution Concentrate is a natural botanical that removes mold spores, bacteria,...
-
$33.00 Shop Now
Remove harmful pollutants that accumulate in the dust of your home. (Options available for renters...
-
Price range: $99.00 through $349.00 Shop Now
Take your cleaning to the next level buying all the tools we use to keep...
-
Price range: $299.00 through $549.00 Shop Now
Add EC3 to every rinse cycle to rinse away mold, bacteria and musty odors from...
-
$23.00 Shop NowWhile actinomycetes play a vital role in our natural ecosystem, their presence inside your home is a different story. Water-damaged homes, where damp conditions allow actinomycetes to thrive, can become breeding grounds for bacteria and other contaminants like mold. This can negatively impact your health and your indoor air quality.
The good news is that you can prevent actinomycetes from becoming a problem by managing moisture, acting quickly on water damage, and improving ventilation and air quality. Your home is your sanctuary; keeping it free from harmful bacteria is essential to ensuring a healthy living environment for you and your family.
Remember, regular maintenance and quick action after water damage can go a long way in preventing bacterial growth. By following the tips outlined in this blog, you can keep actinomycetes—and their potential health risks—outside where they belong.
References:
https://esmed.org/MRA/mra/article/view/2585
https://www.ncbi.nlm.nih.gov/pmc/articles/PMC5035226/
https://www.sciencedirect.com/topics/agricultural-and-biological-sciences/actinobacteria
https://pubmed.ncbi.nlm.nih.gov/21622270/
https://www.sciencedirect.com/science/article/abs/pii/S0889856122002120

Add EC3 to every rinse cycle to rinse away mold, bacteria and musty odors from...
-
$23.00 Shop Now
Turn your HVAC into the healthiest feature of your home.
-
$2,495.00 Shop Now
Take your cleaning to the next level buying all the tools we use to keep...
-
Price range: $299.00 through $549.00 Shop Now
Remove harmful pollutants that accumulate in the dust of your home. (Options available for renters...
-
Price range: $99.00 through $349.00 Shop Now
Micro Balance EC3 Mold Solution Concentrate is a natural botanical that removes mold spores, bacteria,...
-
$33.00 Shop Now
Optimizing Air Quality starts with finding what’s not optimal. *Detects 36 different species of mold...
-
$299.00 Shop Now
The Euroclean GD930HSP is a 4 Gallon Dry HEPA Vacuum that meets the EPA's standards...
-
$849.00 Shop Now